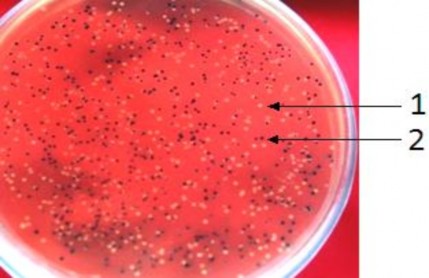
Hình 3 7 Khuẩn lạc xanh trắng xuất hiện trên môi trường LBA sau khi nuôi cấy 7

Bảng 3.1. Sự đa dạ ng hình thái tinh thể của các chủng Bt
Hình dạng tinh thể | Số chủng | Tỷ lệ % | |
1 | Lưỡng tháp | 21 | 39 |
2 | Cầu | 4 | 7 |
3 | Lưỡng tháp và cầu | 26 | 48 |
4 | Lập phương | 1 | 2 |
5 | Cầu và lập phương | 1 | 2 |
6 | Không xác định | 1 | 2 |
Tổng số | 54 | 100 | |
Có thể bạn quan tâm!
-
Nghiên cứu đặc điểm sinh học của một số chủng Bacillus Thuringiensis sinh Protein tinh thể diệt côn trùng cánh vảy - 1 -
Nghiên cứu đặc điểm sinh học của một số chủng Bacillus Thuringiensis sinh Protein tinh thể diệt côn trùng cánh vảy - 2 -
Mô Hình Cấu Trúc Không Gian 3 Chiều Của Protein Độc Tố Cry1Ac -
Gene Cry1C Và Dưới Loài Bacillus Thuringiensis Subsp . Aizawai -
Phân Loại Các Chủng Bt Bằng Phản Ứng Huyết Thanh -
Nghiên cứu đặc điểm sinh học của một số chủng Bacillus Thuringiensis sinh Protein tinh thể diệt côn trùng cánh vảy - 7
Xem toàn bộ 63 trang tài liệu này.

Hình 3.2. Hình dạng bào tử và tinh thể của Bt phóng đại 1000 lần dưới kính hiển vi quang học (1: tinh thể, 2: bào tử)
54 chủng B. thuringiensis sinh tổng hợp các lọai protein tinh thể rất đa dạng. Trong đó, protein tinh thể hình lưỡng tháp và hình cầu chiếm tỷ lệ cao nhất 48%, sau đó là protein tinh thể lưỡng thấp chiếm 39%. Các chủng sinh tinh thể hình cầu, lập phương và đồng thời 2 loại tinh thể này chiếm tỷ lệ tương đối thấp, từ 2% đến 7%. Điều này thể hiện tính đa dạng về hình dạng tinh thể của các chủng B. thuringiensis đã phân lập. Sự khác nhau về cấu trúc cũng như hình
dạng tinh thể là do thành phần protein cấu tạo tinh thể tạo nên. Sự phong phú về hình dạng tinh thể là cơ sở tạo nên phổ diệt côn trùng rộng từ cánh vảy, bộ hai cánh đến bộ cánh cứng tới giun tròn thực vật.
Theo nhiều tài liệu đã công bố, dưới loài Bta mang nhiều gene trong họ gene cry1 trong đó có gene cry1C có khả năng mã hóa protein tinh thể hình lưỡng tháp và hình cầu có khả năng diệt côn trùng bộ cánh vảy với hoạt lực cao. Vì vậy, các chủng Bt phân lập được phân loại bằng huyết thanh để xác định dưới loài của chúng nhằm tìm ra các chủng Bta và thử hoạt tính diệt côn trùng bộ cánh vảy với sâu tơ.
3.1.2 Phân loại Bt bằng huyết thanh
Phân loại dưới loài theo phương pháp phân loại huyết thanh của de Barjac và Bonefoi đối với các chủng nghiên cứu. Bt được chia làm rất nhiều dưới loài khác nhau, mỗi dưới loài mang các đặc điểm riêng biệt. Dưới loài Bta có khả năng diệt côn trùng bộ cánh vảy thuộc type huyết thanh H7. Để tìm được các chủng Bta chúng tôi tiến hành sàng lọc các chủng Bt phân lập bằng cách sử dụng typ huyết thanh H7 để phân loại.
Với 26 chủng nghiên cứu mang tinh thể hình lưỡng tháp và hình cầu,
chúng tôi đã xác định được 10 chủng có phản ứng dương tính với typ huyết thanh H7 chiếm 38% số chủng được phân loại (Hình 3.3).
Như vậy có thể bước đầu kết luận rằng có 10 chủng nghiên cứu có khả
năng thuộc dưới loài Bta.

A B
Hình 3.3. Sản phẩm ngưng kết huyết thanh của chủng TN 6.12 phân lập với typ huyết thanh dưới kính hiển vi quang học độ phóng đại 400 lần
A: Trước khi nhỏ huyết thanh miễn dịch B: Sau khi nhỏ huyết thanh miễn dịch
3.1.3 Hoạt tính diệt của các chủng Bta trên sâu xanh da láng và sâu tơ
Nồng độ bào tử
Bt trong giai đoạn tạo bào tử đồng thời sinh tổng hợp các tinh thể độc. Thông qua nồng độ bào tử có thể gián tiếp ước lượng nồng độ tinh thể của các chủng nghiên cứu. Do đó chúng tôi tiến hành xác định nồng độ bào tử của 7 chủng Bta nghiên cứu cùng với chủng Bta chuẩn 4J4 làm đối chứng dương.
Nồng độ bào tử của các chủng Bta dao động từ 2,5109 đến 5109 bào tử/ml.
Chúng tôi đã chọn ra 7 chủng Bta TN 1.12, TN 3.4, TN 4.4, TN5.3, TN 6.12, TN 28.6 và TN 36.3 có nồng độ bào tử cao để xác định hoạt tính diệt côn trùng thử nghiệm.
Sinh khối của 7 chủng Bta được pha loãng nhiều lần, chúng tôi sử dụng nồng độ 105 và 107 bào tử/ml để thử hoạt tính diệt sâu tơ và nồng độ 107 và 109 bào tử/ml diệt sâu xanh da láng.
Hoạt tính của các chủng Bta diệt sâu xanh da láng và sâu tơ
Hoạt tính diệt sâu da láng
Bảy chủng Bta đươc pha loãng tới nồng độ 107 và 109 bào tử/ml bằng nước cất vô trùng. Tiến hành thử nghiệm trên đối tượng sâu xanh da láng theo công thức của Abbott. Tỷ lệ sâu chết được tính sau 3 ngày thử nghiệm. Kết quả thử nghiệm được trình bày ở Hình 3.4 và Bảng 3.2.

Hình 3.4. Hoạt tính diệt sâu xanh da láng của các chủng Bta nghiên cứu Bảng 3.2. Hoạt tính diệt sâu xanh da láng của các chủng Bta
sau 3 ngày thử nghiệm
Tên chủng | Tỷ lệ sâu chết (%) | ||
ở nồng độ 107 bào tử/ml | ở nồng độ 109 bào tử/ml | ||
1 | ĐC âm | 0 | 0 |
2 | ĐC dương (4J4) | 33 | 78 |
3 | TN 1.12 | 22 | 56 |
4 | TN 3.4 | 11 | 22 |
5 | TN 4.4 | 11 | 33 |
6 | TN 5.3 | 11 | 44 |
7 | TN 6.12 | 22 | 56 |
8 | TN 28.6 | 22 | 67 |
9 | TN 36.3 | 22 | 55 |
Bảng 3.2 cho thấy 7 chủng Bta đều có hoạt tính diệt sâu xanh da láng. Sau 3 ngày thử nghiệm, 4 chủng TN1.12, TN6.12, TN28.6 và TN 36.3 có hoạt tính
diệt sâu xanh da láng trên 50% ở nồng độ 109 bào tử/ml. Các kết quả thử hoạt tính diệt sâu này là cơ sở để chúng tôi tiến hành các nghiên cứu tiếp theo.
Hoạt tính diệt sâu tơ
Với 7 chủng Bta đã lựa chọn được, chúng tôi thử nghiệm diệt sâu tơ, tỷ lệ sâu chết được theo dòi trong 3 ngày và tính toán theo công thức Abbott. Kết quả thử nghiệm được trình bày trong Hình 3.5 và Bảng 3.3.
|
Hình 3.5. Hoạt tính diệt sâu tơ của các chủng Bta nghiên cứu Bảng 3.3: Hoạt tính diệt sâu tơ của các chủng Bt
sau 3 ngày thử nghiệm
Tên chủng | Tỷ lệ sâu chết (%) | ||
Ở nồng độ 105 bào tử/ml | Ở nồng độ 107 bào tử/ml | ||
1 | ĐC âm | 0 | 0 |
2 | ĐC dương (4J4) | 77 | 93 |
3 | TN 1.12 | 53 | 80 |
4 | TN 3.4 | 63 | 83 |
5 | TN 4.4 | 50 | 77 |
6 | TN 5.3 | 53 | 80 |
7 | TN 6.12 | 57 | 80 |
8 | TN 28.6 | 60 | 87 |
9 | TN 36.3 | 53 | 83 |
Bảng 3.3 cho thấy tất cả các chủng Bta TN 1.12, TN 3.4, TN 4.4, TN5.3, TN 6.12, TN 28.6 và TN 36.3 đã lựa chọn đều có hoạt tính diệt sâu tơ tương đối cao. Sau 3 ngày thử hoạt tính đa số các chủng đều cho tỷ lệ sâu chết lớn hơn 50%, ở cả hai nồng độ pha loãng. Đặc biệt tất cả các chủng trừ TN 4.4 khi thử ở nồng độ 107 bào tử/ml đều có tỷ lệ sâu chết lên tới hơn 80%.
Qua kết quả thử hoạt tính của các chủng Bta diệt 2 loại côn trùng thử nghiệm có thể kết luận như sau:
- 7 chủng Bta nghiên cứu đều có hoạt tính diệt cả 2 loại côn trùng thử nghiệm.
- Các chủng TN28.6,TN1.12, TN6.12, và TN36.3 đều có hoạt tính diệt cao đối với cả 2 loại côn trùng thử nghiệm.
Các kết quả thử hoạt tính diệt sâu nói trên là cơ sở để chúng tôi tiến hành các nghiên cứu tiếp theo về gene mã hóa độc tố tinh thể.
3.2 Tách dòng và đọc trình tự đoạn gene cry1C
3.2.1 Khuếch đại gene cry1C của các chủng Bta bằng PCR
Nhóm gene cry1C mã hóa protein tinh thể có khả năng diệt côn trùng bộ cánh vảy. Để phát hiện gene độc tố này chúng tôi sử dụng phương pháp PCR nhằm khuếch đại một đoạn của gene cry1C của 7 chủng Bta có hoạt tính diệt sâu với cặp mồi đặc hiệu. Theo tính toán lý thuyết, sản phẩm đoạn gene cry1C với cặp mồi đặc hiệu có kích thước 288 bp.
Sản phẩm PCR được điện di kiểm tra trên gel agarose 1% (Hình 3.6).

Hình 3.6. Điện di đồ sản phẩm PCR của các chủng Bta nghiên cứu
Giếng 1, 2, 3, 4, 5, 6, 7, 8: TN 1.12, TN 3.4, TN 4.4, TN 5.3,
TN 6.12, TN 28.6, TN 36.3, ĐC dương
M: DNA Marker
Hình 3.6 cho thấy sản phẩm PCR có duy nhất một băng với kích thước khoảng 300 bp. Như vậy các chủng thuộc dưới loài Bta nghiên cứu đều có thể mang gene cry1C.
Để khẳng định các chủng này chắc chắn mang gene cry1C hay không, chúng tôi chọn 2 chủng TN 6.12 và TN 28.6 để tách dòng đoạn gene cry1C và xác định trình tự của chúng.
3.2.2 Tách dòng đoạn gene cry1C
Gắn sản phẩm PCR vào vector tách dòng pGEM-T Easy
Vector pGEM-T Easy tồn tại ở dạng mạch thẳng với 2 đầu tự do đều thừa ra 1 nucleotide T nên dễ dàng bắt cặp theo nguyên tắc bổ sung với đầu so le A của sản phẩm PCR (Taq polymerase có hoạt tính gắn thêm 1 adenine vào đầu 3’ khi kết thúc PCR) vì thế chúng tôi chọn vector pGEM-T Easy làm vector tách dòng.
Đoạn gene tính toán theo lý thuyết 288 bp thu được từ sản phẩm PCR của 2 chủng TN 6.12 và chủng TN 28.6 được gắn trực tiếp vào vector pGEM-T Easy. Sản phẩm là vector tái tổ hợp pGEM-T Easy- cry1C-TN 6.12 và pGEM- T Easy-cry1C-TN 28.6.
Biến nạp vector tái tổ hợp vào vi khuẩn E. coli DH5α
Tiến hành biến nạp 2 vector tái tổ hợp trên vào tế bào khả biến E.coli DH5α bằng phương pháp sốc nhiệt như đã trình bày trong phần phương pháp. Sau khi biến nạp, chủng E.coli DH5α mang vector tái tổ hợp pGEM-T Easy- cry1C được nuôi cấy trên môi trường LB + ampicillin + X-gal ở 37ºC qua đêm thấy xuất hiện những khuẩn lạc màu xanh và trắng trên mặ t thạ ch (Hình 3.7).
Hình 3.7. Khuẩn lạc xanh, trắng xuất hiện trên môi trường LBA sau khi nuôi cấy qua đêm. (1: Khuẩn lạc trắng, 2: khuẩn lạc xanh)
Các dòng vi khuẩn mọc được trên môi trường chứa ampicillin là các dòng đã được biến nạp vector pGEM-T Easy có gene kháng kháng sinh.
Khuẩn lạc xanh xuất hiện là do promoter của lac - operon trên vectơ pGEM-T Easy vẫn hoạt động bình thường nên β- galactosidase vẫn được tổng hợp và có khả năng chuyển hóa X-gal từ không màu sang màu xanh chàm.
Khuẩn lạc trắng xuất hiện là do hai nguyên nhân sau: nguyên nhân thứ nhất có thể là do tế bào vi khuẩn nhận được vector tái tổ hợp mang đoạn DNA chèn vào giữa gene cấu trúc lacZ làm hỏng promoter của gene lac-operon trong vector pGEM–T Easy nên trong quá trình sống nó không tạo ra β- galactosidase, không có khả năng chuyển hoá được cơ chất X- gal có trong môi trường nuôi cấy vi khuẩn vì vậy mà không có màu xanh. Nguyên nhân thứ hai có thể là do promoter điều khiển hoạt động của gene mã hoá cho β - galactosidase bị hỏng, dẫn đến không tổng hợp được β- galactosidase do đó mà vi khuẩn E. coli không chuyển hoá được X-gal có trong môi trường nên tạo thành các khuẩn lạc màu trắng.
Để biết các khuẩn lạc trắng có mang gene mong muốn hay không, kiểm tra bằng cách cắt DNA plasmid và tinh sạch. Các dòng khuẩn lạc trắng được cấy vào môi trường LB bổ sung ampicillin nuôi lắc qua đêm để tách plasmid.








